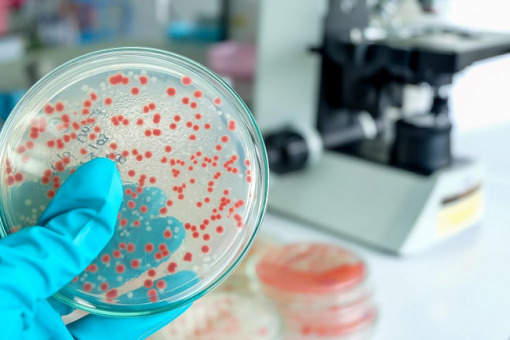

Narasta problem z opornością na leki. Potrzebne nowe rozwiązania
Oporność na środki przeciwdrobnoustrojowe jest jednym z trzech największych zagrożeń dla zdrowia w Unii Europejskiej. Aby zminimalizować to niebezpieczeństwo, Rada UE powinna wytworzyć system zachęt do tworzenia nowych środków przeciwdrobnoustrojowych i zwiększyć dostępność do już istniejących.
W ocenie Konfederacji Lewiatan, aby skutecznie zwalczać oporność drobnoustrojów na kluczowe leki, Unia Europejska powinna przygotować program zachęt dla przedsiębiorców, w celu zmotywowania ich do działań na rzecz walki z opornymi patogenami. Mógłby on polegać na systemie gwarancji z przychodu, premiach i być finansowany czy współfinansowany przez UE.
Czym są środki przeciwdrobnoustrojowe?
Środki przeciwdrobnoustrojowe to leki do profilaktyki i leczenia infekcji u ludzi, zwierząt i roślin. Zaliczają się do nich antybiotyki, środki przeciwwirusowe, przeciwgrzybicze i przeciwpasożytnicze.
Zdaniem unijnego Urzędu ds. Gotowości i Reagowania na Stany Zagrożenia Zdrowia (HERA) oporność na środki przeciwdrobnoustrojowe jest jednym z trzech największych zagrożeń dla zdrowia w UE. Oznacza to, że np. bakterie czy wirusy przestają na nie reagować. Antybiotyki i inne leki przeciwdrobnoustrojowe tracą moc. Infekcje stają się trudniejsze i często niemożliwe do wyleczenia.
W listopadzie br. Europejskie Centrum Zapobiegania i Kontroli Chorób (ECDC) opublikowało nowe dane, z których wynika, że w latach 2019–2022 zaobserwowano spadek spożycia antybiotyków o 2,5 proc. Jednak ten spadkowy trend został odwrócony w 2022 r., kiedy społeczeństwo wróciło do stylu życia sprzed pandemii COVID-19 i częstotliwość zachorowania na wirusy oddechowe się zwiększyła. Szacuje się, że koszt oporności na środki przeciwdrobnoustrojowe wynosi w UE 11,7 miliarda euro rocznie.
Potrzebny unijny program zachęt
– Unia powinna opracować dotyczący wielu krajów program zachęt typu pull (wsparcia sprzedaży) rozwoju nowych środków przeciwdrobnoustrojowych oraz dostępu do już istniejących. Program ten mógłby np. przyjąć formę gwarancji przychodu, premii za wejście na rynek połączonych z gwarancją przychodu lub płatności za osiągnięcie kamienia milowego oraz mógłby być finansowany lub współfinansowany przez UE. Oporność na środki przeciwdrobnoustrojowe jest problemem o tak dużej skali, że bez wysiłku na szczeblu unijnym państwa członkowskie nie będą w stanie sobie z nim poradzić – ostrzega Kacper Olejniczak, ekspert ds. branży life sciences Lewiatana.
Zalecenia Rady UE w sprawie oporności na środki przeciwdrobnoustrojowe koncentrują się m.in. na zapobieganiu zakażeniom i ich kontroli, nadzorze i monitorowaniu, dostępności skutecznych środków przeciwdrobnoustrojowych czy rozważnym ich stosowaniu.
Na rok 2030 wyznaczono kilka celów UE, opracowanych we współpracy z ECDC. To m.in. zmniejszenie o 20 proc. spożycia antybiotyków u ludzi i ograniczenie zakażeń trzema kluczowymi bakteriami opornymi na antybiotyki – co będzie dotyczyć głównie szpitali.
Opracowanie: INK
Czym są środki przeciwdrobnoustrojowe?
Środki przeciwdrobnoustrojowe to leki do profilaktyki i leczenia infekcji u ludzi, zwierząt i roślin. Zaliczają się do nich antybiotyki, środki przeciwwirusowe, przeciwgrzybicze i przeciwpasożytnicze.
Zdaniem unijnego Urzędu ds. Gotowości i Reagowania na Stany Zagrożenia Zdrowia (HERA) oporność na środki przeciwdrobnoustrojowe jest jednym z trzech największych zagrożeń dla zdrowia w UE. Oznacza to, że np. bakterie czy wirusy przestają na nie reagować. Antybiotyki i inne leki przeciwdrobnoustrojowe tracą moc. Infekcje stają się trudniejsze i często niemożliwe do wyleczenia.
W listopadzie br. Europejskie Centrum Zapobiegania i Kontroli Chorób (ECDC) opublikowało nowe dane, z których wynika, że w latach 2019–2022 zaobserwowano spadek spożycia antybiotyków o 2,5 proc. Jednak ten spadkowy trend został odwrócony w 2022 r., kiedy społeczeństwo wróciło do stylu życia sprzed pandemii COVID-19 i częstotliwość zachorowania na wirusy oddechowe się zwiększyła. Szacuje się, że koszt oporności na środki przeciwdrobnoustrojowe wynosi w UE 11,7 miliarda euro rocznie.
Potrzebny unijny program zachęt
– Unia powinna opracować dotyczący wielu krajów program zachęt typu pull (wsparcia sprzedaży) rozwoju nowych środków przeciwdrobnoustrojowych oraz dostępu do już istniejących. Program ten mógłby np. przyjąć formę gwarancji przychodu, premii za wejście na rynek połączonych z gwarancją przychodu lub płatności za osiągnięcie kamienia milowego oraz mógłby być finansowany lub współfinansowany przez UE. Oporność na środki przeciwdrobnoustrojowe jest problemem o tak dużej skali, że bez wysiłku na szczeblu unijnym państwa członkowskie nie będą w stanie sobie z nim poradzić – ostrzega Kacper Olejniczak, ekspert ds. branży life sciences Lewiatana.
Zalecenia Rady UE w sprawie oporności na środki przeciwdrobnoustrojowe koncentrują się m.in. na zapobieganiu zakażeniom i ich kontroli, nadzorze i monitorowaniu, dostępności skutecznych środków przeciwdrobnoustrojowych czy rozważnym ich stosowaniu.
Na rok 2030 wyznaczono kilka celów UE, opracowanych we współpracy z ECDC. To m.in. zmniejszenie o 20 proc. spożycia antybiotyków u ludzi i ograniczenie zakażeń trzema kluczowymi bakteriami opornymi na antybiotyki – co będzie dotyczyć głównie szpitali.
Opracowanie: INK




